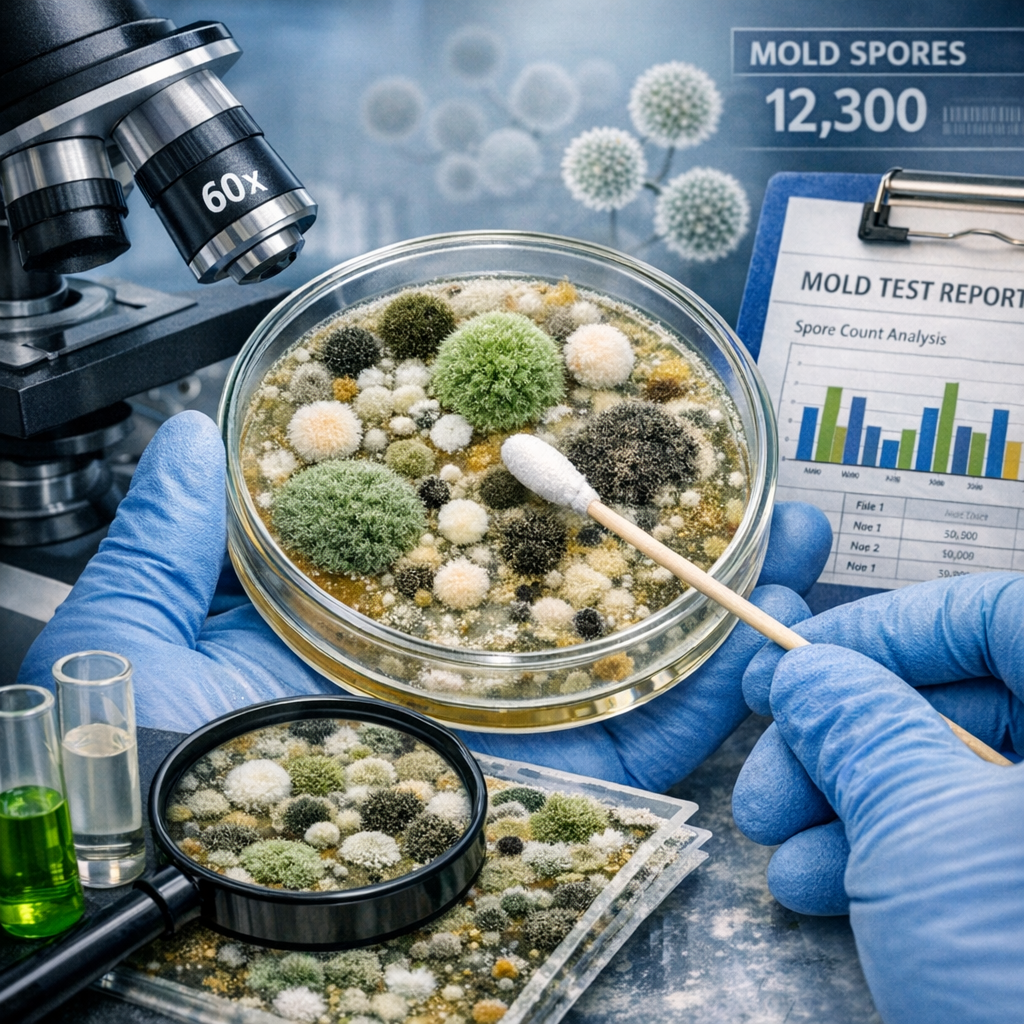

Mold Analysis
Sporelytics is a premier commercial mold testing laboratory in the United States, trusted nationwide and internationally for accuracy, reliability, and scientific rigor. We deliver legally defensible results on the same day your samples are received, ensuring rapid turnaround without compromising quality. Every sample undergoes analysis of 100% trace at 600x magnification, providing the highest level of analytical detail and confidence in your data. Our clients also benefit from responsive, knowledgeable customer support designed to make your work easier and more efficient. Environmental consultants, industrial hygienists, and mold inspectors have relied on our laboratory for years because of our commitment to precision, consistency, and exceptional service. When you need a mold testing partner you can trust, choose Sporelytics for uncompromising quality and dependable results.
Flexible, Professional Reporting Options
Your data can be seamlessly integrated into a variety of innovative report formats. Choose the reporting style that best fits your project, your clients, and your documentation needs.
-
 The fastest turnaround time in the industry
The fastest turnaround time in the industry
-
 Rigid Quality Control
Rigid Quality Control
-
 24/7 Technical Support
24/7 Technical Support
Mold Lab Testing Services

Direct Microscopy Air Analysis
- A001- Standard Spore Trap Analysis
- A002- Expanded Spore Trap Analysis
(Standard Analysis Plus Fibers, Fiberglass, Insect Parts, Skin Cells)

Direct Microscopy Surface Sample Analysis (Swab)
- S001- Standard Quantitative Spore Count by Direct Exam
- S002- Expanded Quantitative Spore Count by Direct Exam
(Standard Analysis Plus Fibers, Fiberglass, Insect Parts, Skin Cells, Pollen)

Direct Microscopy Surface Sample Analysis (Dust, Tapes, Bulks)
- T001- Standard Quantitative Spore Count by Direct Exam
- T002- Expanded Quantitative Spore Count by Direct Exam
(Standard Analysis Plus Fibers, Fiberglass, Insect Parts, Skin Cells, Pollen)
Free Equipment Support for Your Assessment
At Sporelytics, we make sure you’re fully equipped to perform a high‑quality assessment. If your air pump isn’t working, or if you’d like to try a different model before purchasing, we’re happy to provide a complimentary rental.
Free Pump Rentals:
 Bio‑Pump IAQ Lite
Bio‑Pump IAQ Lite Buck BioAire Pump
Buck BioAire Pump Z-Lite Pump
Z-Lite Pump
All Sporelytics clients also receive free swabs and tape‑lift kits.
Need to purchase a new pump? We can help with that too. Our team can guide you toward reliable, industry‑standard options that fit your workflow.
Purchase Supplies

Other Environmental Services
Sporelytics scientists bring extensive expertise across a wide range of environmental testing procedures. If you’re dealing with questions outside of mold, or you don’t see the specific service you’re looking for, we’re here to help.
Whether you need guidance, clarification, or support on a unique environmental challenge, our team is ready to assist.


